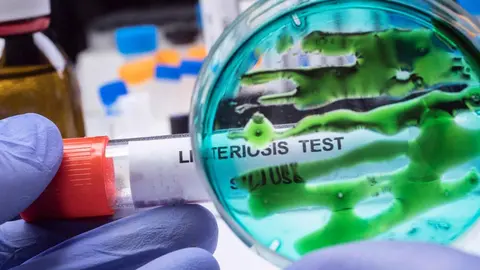

Nueva alerta sanitaria en Andalucía, más concretamente en las provincias de Sevilla y Cádiz, donde han sido retirados del mercado un lote de chorizo de la marca Chacinas El Bosque por la posible presencia de listeriosis.
De esta manera, la Dirección General de Salud Pública y Ordenación Farmacéutica ha tenido conocimiento de la existencia de Listeria monocytogenes en un lote de chorizo elaborado por la misma empresa, que lo ha comercializado en diferentes presentaciones (rosario y herradura). Este aviso se suma a la alerta reciente por una morcilla en la provincia de Cádiz.
Retiran por listeriosis un lote de chorizo elaborado por 'Chacinas El Bosque' https://t.co/l9ZpdP6aMC pic.twitter.com/LmGoIgr5Mv
— MARTINEZ&SANTIAGO (@Cirosmith69) October 14, 2022
Como suele ser preceptivo en estos casos se ha tomado la decisión de inmovilizar y retirar del mercado el chorizo rosario, chorizo rosario picante, chorizo herradura y chorizo herradura picante de las marcas 'Chacinas El Bosque' y 'Hermanos Gómez Jiménez de Villamartín'.
Chorizo retirado del mercado en Sevilla y Cádiz
En función de las actuaciones realizadas hasta el momento, los productos han sido distribuidos por estas dos empresas a destinatarios en las localidades gaditanas de:
- Villamartín
- Sanlúcar de Barrameda
- El Bosque
- Prado del Rey
- Benamahoma
- Jerez de La Frontera
- Chipiona
- Zahara de la Sierra
- Grazalema
- Algodonales
La empresa, y en aplicación del principio de precaución, la empresa está retirando los productos elaborados. En concreto, se trata de:
- Cabeza de lomo
- Salchichón extra
- Salchichón ibérico casero
- Cuche y morcilla cocida de la marca Chacinas El Bosque
- Chorizo picante rosario
- Chorizo rosario
- Chorizo herradura de las marcas Chacinas El Bosque y Hermanos Gómez Jiménez de Villamartín S.L
- Morcilla El Bosque de Hermanos Gómez Jiménez de Villamartín S.L.
- Buche pardo
- Morcilla de hígado de la marca Gourmet del Sur
Estos productos fueron distribuidos por la empresa en la provincia de Cádiz, Sevilla (Los Palacios y Sevilla capital) y las unidades de cabeza de lomo mechada también a un punto de venta de otros lugares de España. Se recomienda a las personas que pudieran tener en su domicilio este producto objeto de la alerta y de la información se abstengan de consumirlo y lo devuelva al punto de compra.
Personas asintomáticas
En personas sanas, generalmente la infección por Listeria monocytogenes suele ser asintomática o cursa con una sintomatología gastrointestinal leve, fiebre y dolores musculares. Sin embargo, en determinados grupos de riesgo, como personas inmunodeprimidas, personas de edad avanzada, niños pequeños y embarazadas pueden presentarse cuadros más graves.
En caso de estar embarazada, se recomienda consultar las recomendaciones de consumo durante el embarazo de la Agencia Española de Seguridad Alimentaria y Nutrición (AESAN) que incluyen información sobre buenas prácticas de higiene alimentaria importantes para las mujeres gestantes.